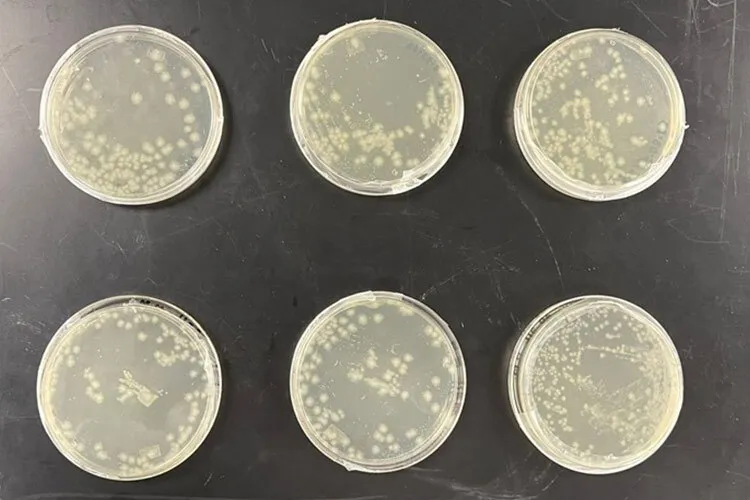

Researchers have developed a groundbreaking self-healing concrete capable of sealing small cracks. This advancement means that building walls could essentially “heal” themselves, similar to how our skin regenerates after injuries and scrapes.
This innovation is made possible by a bacterial additive that helps the concrete form calcium carbonate, a white powder commonly seen as limescale in showers and sinks. Calcium carbonate has been associated with self-healing properties observed in ancient construction materials, including structures nearly 2,000 years old, such as the Pantheon in Rome and the Roman Colosseum.
“This material has a specific hardness and is chemically very stable. It forms naturally from calcium alone, but bacteria accelerate the transformation into calcium carbonate,” explains Alejandro Montesinos, head of the Decarbonization, Climate Change, and Circular Economy Research Group at Tec de Monterrey and a member of the Institute of Advanced Materials and Sustainable Manufacturing.
Researchers have tested this type of bacteria for the past few years, particularly Bacillus subtilis, which feeds on CO2 and possesses biomineralization properties. In other words, during its metabolic process, it produces calcium carbonate.
Among its various benefits, this material also aims to address the CO2 emissions generated by the cement industry. With approximately 2.3 billion tons of CO2 emissions annually, the industry is one of the significant contributors to global greenhouse gas emissions, accounting for nearly 7% of the total.

CO2 and Bacteria: The Foundation for Self-Healing Concrete
When calcium oxide is combined with CO2, it naturally forms calcium carbonate over time due to thermodynamic equilibrium, explains the researcher. This process can be simplified and accelerated with the help of bacteria.
“Stalactites are a prime example; bacteria aid in their formation. It’s not just the water with its calcium and magnesium content, but also the bacteria and the biochemical process that promote their development,” he notes.
Like similar organisms, Bacillus subtilis requires moisture and feeds on nutrients like calcium and magnesium to grow and reproduce. In its metabolism, it uses ions from these minerals, captures CO2, and combines them to form carbonates, eventually turning into rock.
As it consumes calcium and CO2, the bacterium turns carbonate in a biomineralization process that the researcher compares to dinosaur fossils—essentially, the bacteria become rock and seal the cracks.
Additionally, as a mode of defense and survival, the bacteria go through a self-sacrificing phase where they die, but not before reproducing and laying spores ready for the next generation when conditions are right.
These characteristics make the bacteria valuable as an additive to give concrete, based on carbonates and various mineral bonds, the ability to self-repair. In buildings, this would function similarly to the healing process in human skin.
Training Bacteria to Survive in Concrete
First, it’s crucial to ensure bacteria can survive in concrete to enable them to produce calcium carbonate. Concrete’s high pH and alkalinity make it a harsh environment where most microorganisms cannot thrive.
This presents a major challenge for researchers who “train” the bacteria to withstand the pH conditions of concrete, even when it’s mixed with water.
“If you just put any Bacillus subtilis strain in concrete, it’s likely to die and fail to grow or reproduce. The challenge is to get the bacteria to adapt so that when we introduce it into the concrete, it won’t perish,” the researcher explains.
To address this, they mix bacterial spores into the concrete, embedding them in a protective matrix. If the concrete develops a crack, the spores become exposed, germinate, and the bacteria grow again. With adequate moisture, nutrients, and CO2, the bacteria will carry out mineralization.
In controlled laboratory conditions, self-repair can take 15 days to a month, depending on the crack size. For instance, tests on cracks about one to two millimeters wide and 12 centimeters long took around 30 days to heal.
Researchers are halfway through this project. The next steps involve preparing the support system to transition from lab tests to real-world, concrete testing in environments with varying humidity levels and CO2 presence.

Aiming for a Construction Industry Solution
Cracks in concrete are a common issue caused by factors like lack of moisture and temperature fluctuations, says Montesinos. He clarifies that the goal of the material being developed in the lab is to address small fissures. Its main application is more aesthetic, aimed at sealing minor cracks.
“It will help with self-repairing small cracks, but it’s not designed for larger fractures in concrete. It’s not suitable for load-bearing walls or structures that need to support weight and develop cracks for some reason,” he explains.
The bacteria can survive in both indoor and outdoor conditions. However, it cannot withstand temperatures above 100°C, such as those encountered during a fire or direct flame exposure. While no tests have confirmed this, the spores may remain dormant for years.
“It’s possible that in 100 years, it could still have this effect. The theory suggests that spores can lie dormant for years and reactivate once the matrix is exposed, perhaps by a scratch, and when moisture reaches it, the mineralization process could start,” the researcher says.
Montesinos envisions self-healing concrete as a solution that could be used as a final layer in construction, akin to plaster and other finishes applied to buildings.
Additionally, he emphasizes that this research provides an alternative to greenhouse gas emissions and promotes circular economy principles.
He notes the importance of rethinking CO2—not as waste to be discarded into the environment but as a valuable resource that can be repurposed for new applications.
Were you interested in this story? Do you want to publish it? Contact our content editor to learn more marianaleonm@tec.mx






